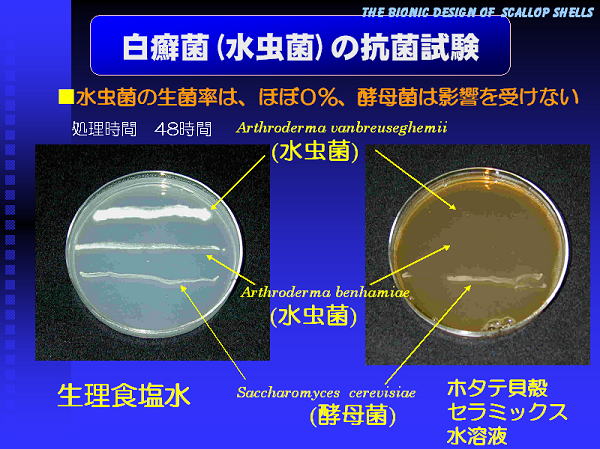

| PowerPoint によるプレゼンテーションの作成 |
|||||||||||||
| 現在、あらゆる分野でプレゼンテーションは必須のものになっています。卒論の発表、学会での講演発表、企画した成果の発表など、見やすく、常に説得力のあるプレゼンであることが必要です。 プレゼンの原稿作成では下記のことに注意しています。
|
|||||||||||||
| などであることが必要です。また、講演会などで聴衆がどのような方であるかも考慮する必要があります。研究者が対象である場合と高校生が対象である場合と同じ内容のプレゼンでは説得力がありません。お互いに貴重な時間を費やして講演し、講演を聴いているのですから、理解されなければお互いに時間の無駄になることを、特に講演をする方は自覚すべきと思います。 |
|||||||||||||
| ■ | 表紙 講演が開始するまで結構投影したままの時間があるので、写真や題目に関係する言葉など入れている。 | ||||||||||||
| 表題の文字と「Scallop Shell」は別のソフトで作成している。 | |||||||||||||
 |
|||||||||||||
| ■ | スライドの背景は、準備されているテンプレートか書式によって作成し、設定可能である。 | ||||||||||||
パソコンが普及する以前は、透明な用紙に原稿をコピーして、オーバーヘッドプロジェクターでスクリーンに投影するものでした。それ以前は、カメラでポジフィルムに撮影して、ネガを1枚1枚ケースに入れて、スライド映写機でスクリーンに投影しました。このフィルムに、ブルーのものがあり、かなりコントラストが良かったので、この時の印象で背景は上のようなブルーを好んで使用しています。文字色は、黄色、白、銀色を主体にしています。 |
|||||||||||||
| ■ | 使用する文字のフォントと大きさ等について | ||||||||||||
| 文字の大きさは、小さくとも18pt以上にしたいと思います。大項目、中項目、小項目の文字の大きさを変える。小さい文字はHG丸ゴシックM-PROを使うことにしている。丸みがあるので優しく見える。丸四角形も優しく感じる。特太ゴシック体はアッピール性が高いと思っている。いずれも、ワープロの「一太郎」のATOK漢字変換プロセッサに付属している。しかし、ATOK漢字変換プロセッサを搭載していないパソコンではすべてゴシック体になります。 |
|||||||||||||
 |
|||||||||||||
| カラーの組み合わせに注意します。 | |||||||||||||
 |
|||||||||||||
| 次の図面は、ホームページのデザインに載っていたカラーチャートの一部です。このチャートがあれば、プレゼンの色の組み合わせにも便利です。 | |||||||||||||
 |
|||||||||||||
| ■ | 写真の挿入 | ||||||||||||
|
|||||||||||||
| ■ | グラフの挿入 | ||||||||||||
| グラフの場合も、プロットのマーカーの大きさ、目盛りの文字の大きさと、軸の名称の文字の大きさのバランスを考慮することが必要です。Excelで作成したグラフを挿入しています。以前は、東北大学理学部の助手の方が作られた素晴らしい科学技術専用のMS-DOSのグラフ用のフリーソフトがありました。おそらく、必要上、ご自分で作成されたと思います。プリンターのドライバーが新しくなる度に組み込む必要がありますので、新機種が発売される度に、対応するだけでも大変だったと思います。 Excelでは余り微妙な調整ができません。また、最近のバージョンはどうか解りませんが、対数の場合、目盛りの表示が、"105"のような表示ができませんので、グラフを図形として貼り付けてから、他のソフトで、"103 104 105"のような文字を入れています。例えば、ExcelからPowerPointに貼り付けて、"103 104 105"の文字をグラフに合うように入力し、全体を他の画像処理ソフトに貼り付けて一体化しています。イラストレータでは指数の表示ができるようです。 |
|||||||||||||
 |
|||||||||||||
| ■ | 図面の挿入 | ||||||||||||
| 図面はJustSystemの「花子」で作成しています。図形処理ソフトは完璧なものが無く、他にも2,3使っています。この種のソフトもバージョンが新しいから必ずしも機能が優れているとは限りませんので、古いバージョンを使うとOSも古いバージョンになってしまいます。素晴らしいソフトでバージョンアップで機能が消えていったソフトは結構あります。図面は自分で描き、オリジナルなものを使うようにしています。説得力があると思っています。 |
|||||||||||||
 |
|||||||||||||
| ■ | アニメーション | ||||||||||||
| アニメーションを使う場合は、次の動作に移るまで聞いている人が、絵と文章を読み終えることが出来るかどうかを考えて作ることが大切です。余り早すぎて消えてしまう場合は意味が分からなくなります。 | |||||||||||||
 |
|||||||||||||
| ■ | ビデオの挿入 以前は標準装備のビデオラムの容量が小さく、ビデオラムの容量を大きくしないと、ビデオファイル再生がコマ落としのようになりました。講演会などでビデオを再生する場合は、ビデオラムを大きくしたノートパソコンを常に持参しました。 |
||||||||||||
 |
|||||||||||||
| * | 以前、1年生に、Word, Excel, PowerPointの使い方等を教えた「情報科学実習」のテキストの原稿の一部です。 | ||||||||||||

